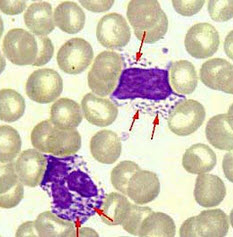

图所示白细胞属哪一种形态异常()A: 棒状小体B: Peger-Huet畸形C: Chediak-Higashi畸形D: Alder-Reillyl畸形E: May-Hegglin畸形
1 阅读
图所示白细胞属哪一种形态异常()
- A: 棒状小体
- B: Peger-Huet畸形
- C: Chediak-Higashi畸形
- D: Alder-Reillyl畸形
- E: May-Hegglin畸形
请帮忙给出正确答案和分析,谢谢!
 搜题,就来89问答库
搜题,就来89问答库